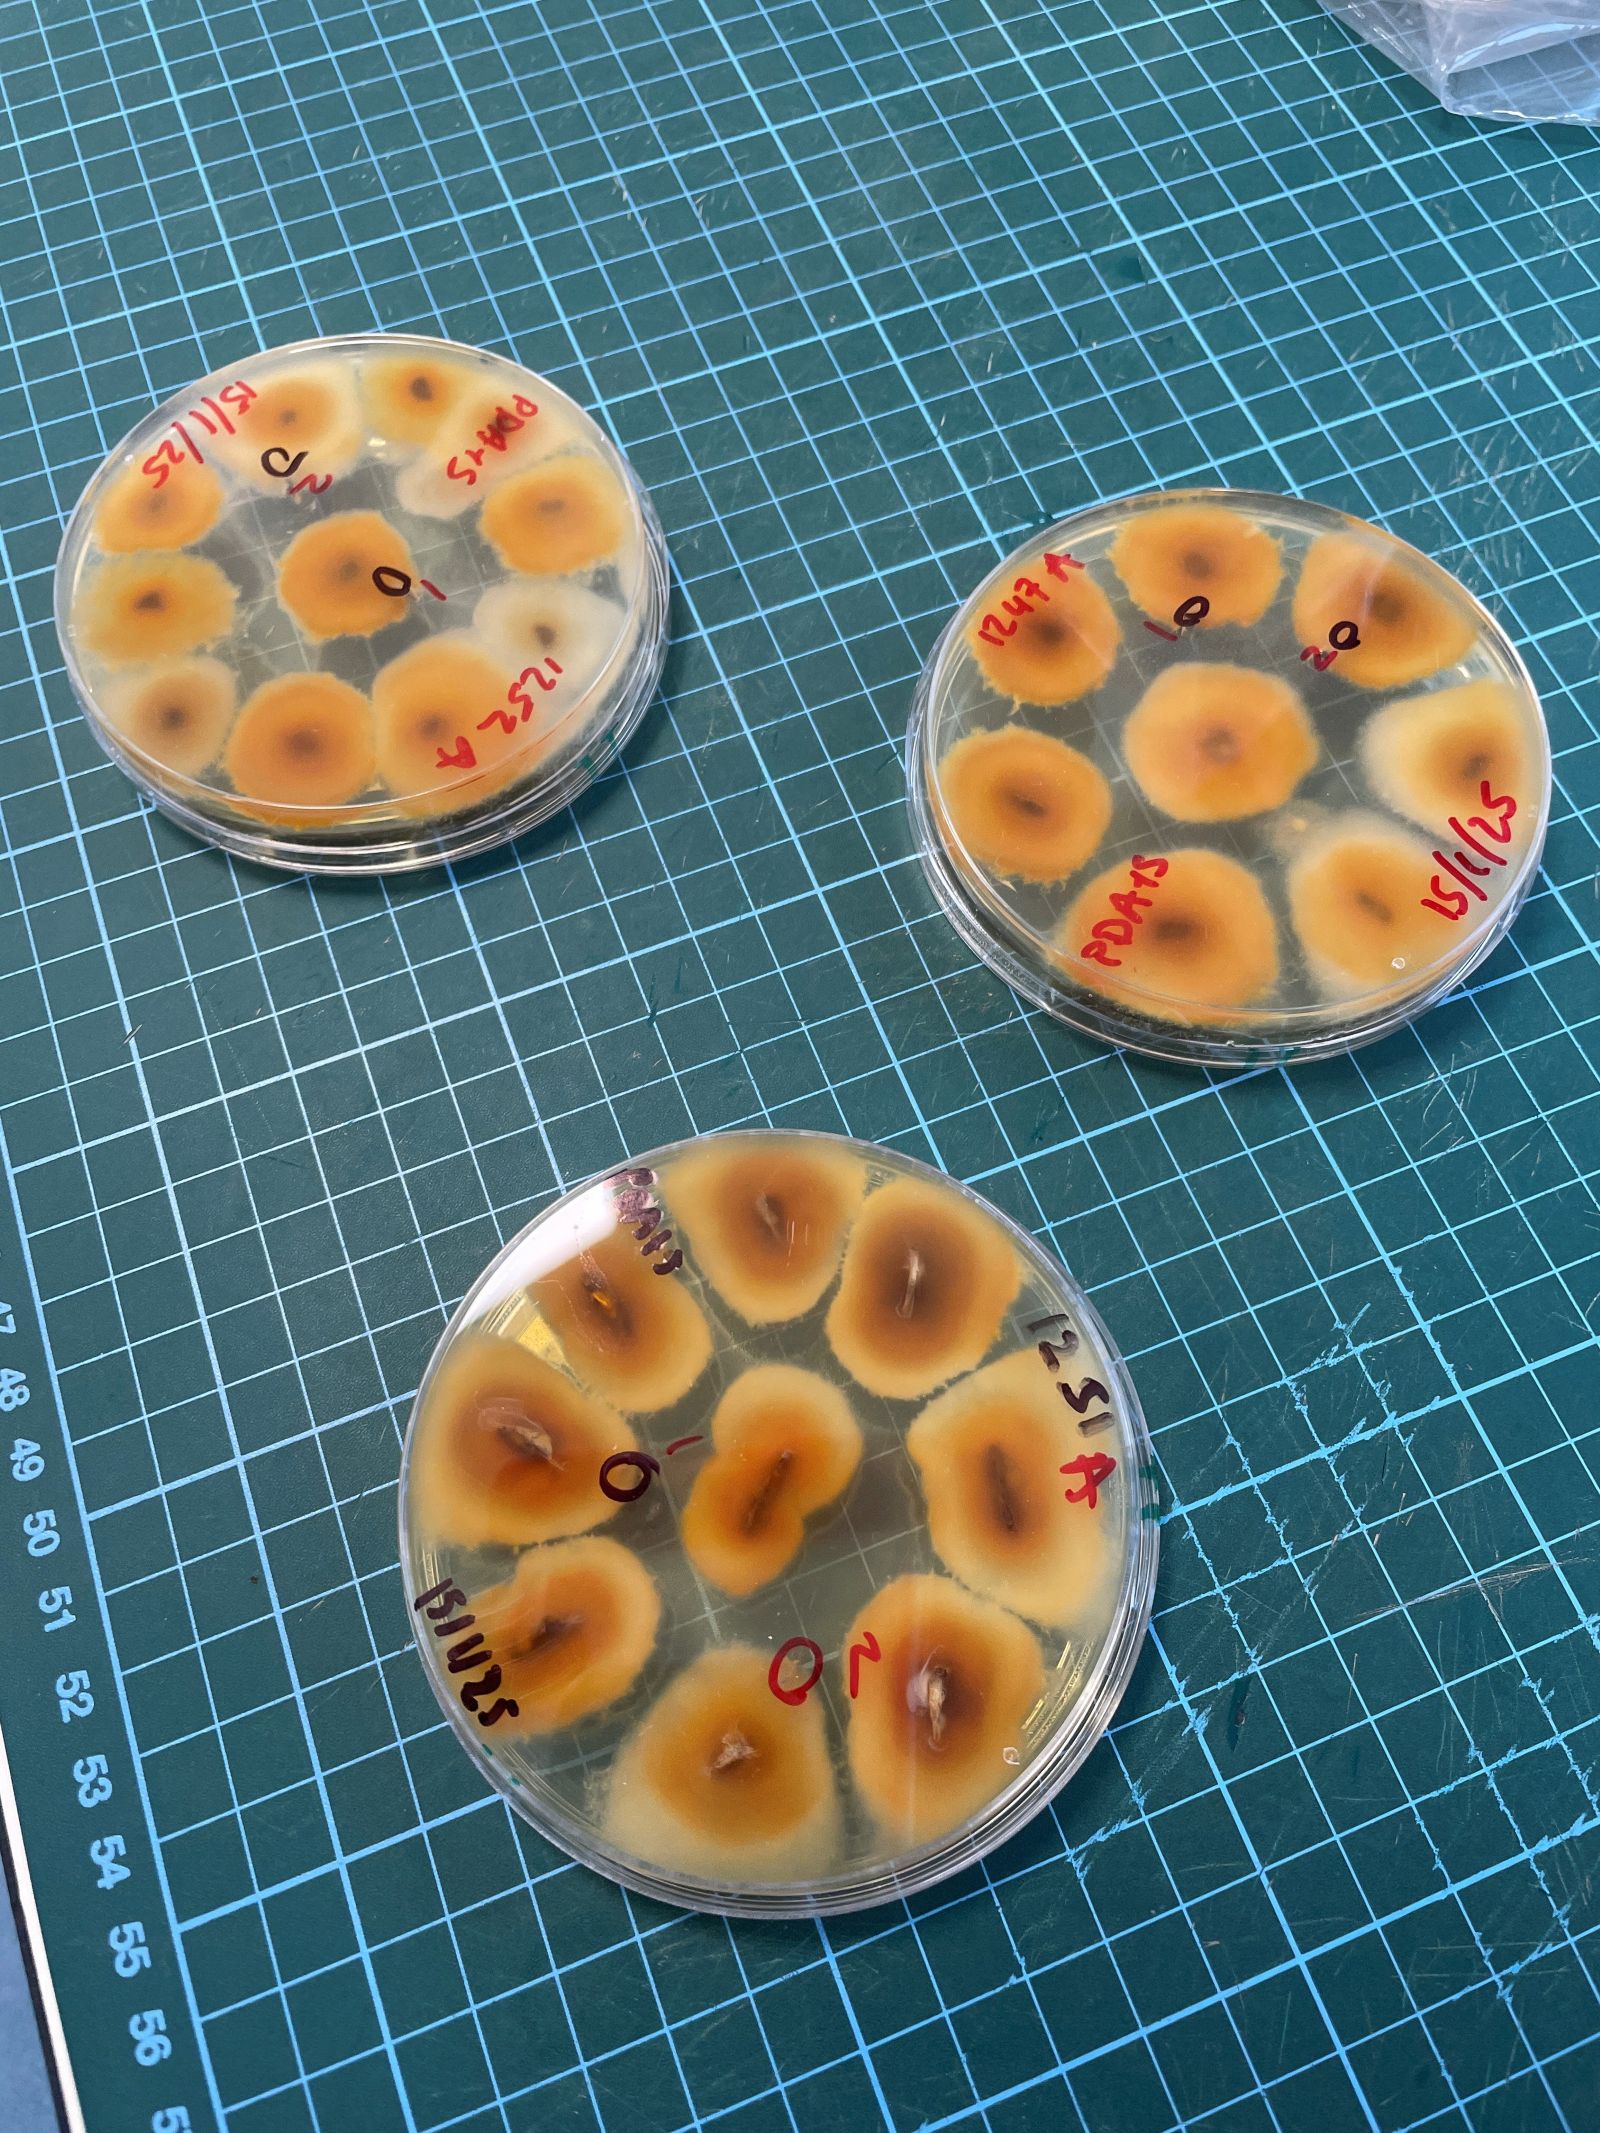
Cryphonectria parasitica isolates in the laboratory. Copyright Forest Research.

As a new outbreak of sweet chestnut blight was identified in Devon, leading to the introduction of a demarcated area, we hear from Mick Biddle, Pathology Response Manager at Forest Research, Great Britain’s principal organisation for forestry and tree-related research, who is working on a trial to assess treatment for sweet chestnut blight disease.
About sweet chestnut blight
Sweet chestnut blight is a tree disease caused by a fungus, Cryphonectria parasitica (C. parasitica). It primarily affects sweet chestnut (Castanea sativa), but it can occasionally affect other species including oaks (although it doesn’t affect horse chestnut trees). The disease can kill sweet chestnut trees and causes a serious, disfiguring decline which is exacerbated by tree stress and drought conditions. Signs of the disease include discoloured and fissured cankers (areas of dead tissue) on stems, with orange pinhead-sized fruiting bodies and buff-coloured fungal fans under the bark.


The pathogen is native to Asia but has been present in mainland Europe since the 1930s. It was first detected in the UK in 2011, likely arriving on planting stock imported in previous decades. It is known to be present in certain areas of southern England.
Where cases of sweet chestnut blight are found in young trees or on a small scale, it is often possible to eradicate disease through the felling and removal of the infected trees and stumps. On sites where the disease is more established, eradication through the destruction of trees can be very difficult and felling interventions may be unsuccessful. However, in these circumstances there could be another way to manage chestnut blight using a biocontrol agent – a naturally-occurring virus which affects C. parasitica. This virus is called Cryphonectria Hypovirus 1, or CHV1 for short.
Sweet chestnut blight can be controlled by introducing CHV1 to the pathogen, which causes an effect called “hypovirulence”. This reduces the ability of the pathogen to harm trees and affects its ability to reproduce and spread. When chestnut blight is present in a tree, it is possible to treat cankers with a compatible “hypovirulent” isolate of C. parasitica. CHV1 then passes to the pathogenic isolate causing the canker, and this allows the canker to heal – often changing colour from orange to black during recovery. The use of CHV1 as a biocontrol agent is undertaken with success in several European countries and once it is established, its positive effect slowly spreads naturally through the movement of the fungus’ waterborne spores.

Ongoing research to gather evidence
At Forest Research, our scientists have been working to understand the diversity of strains of C. parasitica present in the UK. We have shown that CHV1 is effective in reducing disease symptoms under laboratory conditions on the dominant strains of C. parasitica present in the UK. We are also building a bank of hypovirulent fungal strains which would be suitable for use towards the long-term strategic aim – a UK programme of biocontrol to manage sweet chestnut blight where it cannot be eradicated.
The next stage in gathering evidence to enable the successful use of CHV1 is a field trial – going to woodlands and treating infected trees. C. parasitica is a GB Quarantine Pest in our legislation, and we are working closely with Defra and Forestry Commission colleagues to make the licensed use of CHV1 a possibility on mainland UK.
Leading a CHV1 trial in Jersey
While plans are ongoing in the UK to ensure we have the correct legal framework in place to undertake a field trial, Forest Research are working on an exciting project with the Government of Jersey. Sweet chestnut blight in Jersey is quite widely established, and C. parasitica is not considered a Quarantine Pest in Jersey’s legislation. This means we have been able to begin work to treat infected trees in Jersey in a promising trial funded by Defra as part of the Future Proofing Plant Health research programme.

The trial began in January 2025 when Forest Research experts spent time in Jersey, working with the island’s scientists, inspectors and officials to identify suitable sites and trees for treatment. Samples were taken from the infected trees and taken back to our Forest Research quarantine laboratory at the Alice Holt Research Station in Surrey. Once we had determined the dominant C. parasitica isolates, we used techniques we have developed to transmit CHV1 to the pathogenic Jersey samples in the lab.
Treating the infected trees
In July 2025, we went back to Jersey and started treating infected cankers on the selected sweet chestnut trees. The treatment involves using a cork borer to make a series of small holes in the bark, tracing the edge of each canker. Next, the hypovirulent isolate of C. parasitica is inoculated into each incision, and the holes are covered with a sealing compound to prevent secondary infection. Before treatment, each canker is measured and photographed, alongside several untreated control cankers so that we can monitor progress and determine the effect of the biocontrol.


In January 2026, we undertook an initial assessment, six months after making the treatments. The early signs look very promising: our treated cankers have generally not grown in size, while the untreated control cankers appear to have worsened. This means that CHV1 may be having a positive effect and may be starting to become established. It may take several years for cankers to fully heal – we have two more assessments to complete (the project will run until 2027). However, we have already learned a great deal which will help to lay the foundations for the aim of eventually treating infected trees on mainland UK.
Making a difference
The project has been very exciting – the initiative is designed to make a positive difference to the health of Jersey’s trees and it has been a brilliant example of scientific collaboration in action – our Government of Jersey counterparts have been essential in making this joint project possible. And, if the project continues to be successful, it will be an encouraging step towards healthier forests for generations to come, both in Jersey and at home.
If you require any guidance about sweet chestnut blight in Jersey, please contact Stephen Thompson at the Government of Jersey: S.Thompson@gov.je.
Check a Sweet Chestnut this Spring and Summer
Forest Research, working with The Royal Horticultural Society (RHS) and Coventry University, is calling on woodland owners and the public to help check on the health of sweet chestnuts (Castanea sativa) this spring and summer. For more information, visit the latest news story Check a Sweet Chestnut this Spring and Summer – Forest Research.
Recent News
View All newsCalculating the water benefits with the Woodland Water Code (WWC) of newly planted riparian woodland.
Check a sweet chestnut this spring and summer
Forest Research, working with The Royal Horticultural Society (RHS) and Coventry University, is calling on woodland owners and the public to help check on the health of sweet chestnuts (Castanea sativa) this spring and summer.
Trees outside of woodlands identified across Wales
A new national map showing the location of trees outside of woodlands across Wales is now available for the first time.
Calculating the water benefits with the Woodland Water Code (WWC) of newly planted riparian woodland.
Check a sweet chestnut this spring and summer
Forest Research, working with The Royal Horticultural Society (RHS) and Coventry University, is calling on woodland owners and the public to help check on the health of sweet chestnuts (Castanea sativa) this spring and summer.
Trees outside of woodlands identified across Wales
A new national map showing the location of trees outside of woodlands across Wales is now available for the first time.